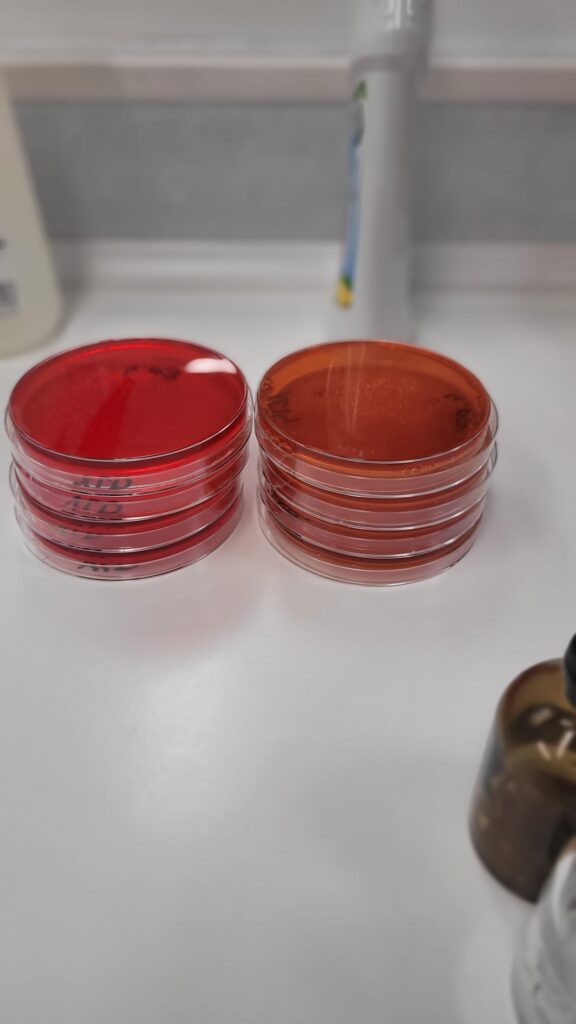

Klasy szóste uczestniczyły w ciekawej lekcji w laboratorium grudziądzkich Wodociągów. Prześledziliśmy drogę wody od ujęcia do kranów, pracowaliśmy na specjalistycznym sprzęcie laboratoryjnym, żeby sprawdzić czystość, barwę , zapach, skład chemiczny. Dowiedzieliśmy się jak wykrywa się bakterie i inne zanieczyszczenia.
Lekcja w Wodociągach odbyła się w ramach programu #AktywniBłękitn